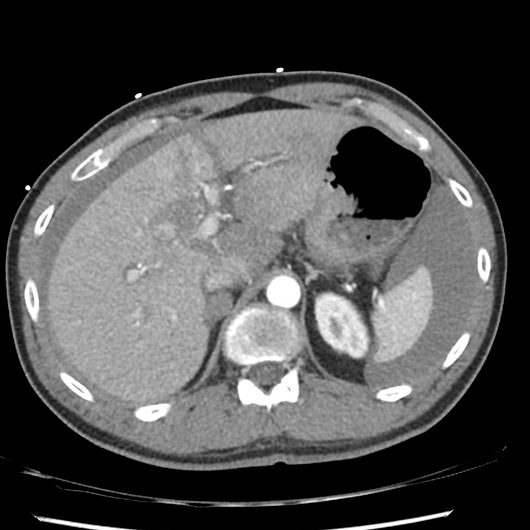

General Surgery & Robotic Surgery
ROBOTIC SURGERY TRAINING IN THE NORTHERN DEANERY
Trainee-Led Evaluation and Evidence-Based Framework for Standardisation in Line with GIRFT Recommendations


Medical Education & Pan-Specialty
THE ROLE OF SUPERVISORS IN POST-GRADUATE SURGICAL EDUCATION
A Mixed Methods Study


Endocrine Surgery & Otolaryngology
THE NORTH EAST THY3 NODULE STUDY
A Multi-Centred Regional Retrospective Case Series


Vascular Surgery & Peri-Operative Medicine
POST-OPERATIVE ANALGESIA FOLLOWING MAJOR LOWER LIMB AMPUTATION
Systematic Review and Meta-Analysis

General Surgery & Trauma Surgery
NON-OPERATIVE MANAGEMENT OF TRAUMATIC ORGAN INJURIES
A Prospective Audit


General Surgery and Surgical Oncology
NEOADJUVANT RECTAL (NAR) SCORE IN LOCALLY ADVANCED RECTAL CANCER
A Survival Analysis Of Patients Undergoing Surgery Post Neo-Adjuvant Chemotherapy


PAN SPECIALTY AND PERI-OPERATIVE MEDICINE
DO FORCED AIR WARMING BLANKETS REDUCE PERI-OPERATIVE HYPOTHERMIA?
A Randomised Control Trial


BREAST SURGERY
POST-OPERATIVE WOUND CARE AND CLINICAL OUTCOMES FOLLOWING BREAST SURGERY
An Evaluation Of Patient Understanding And Adherence to Advice



